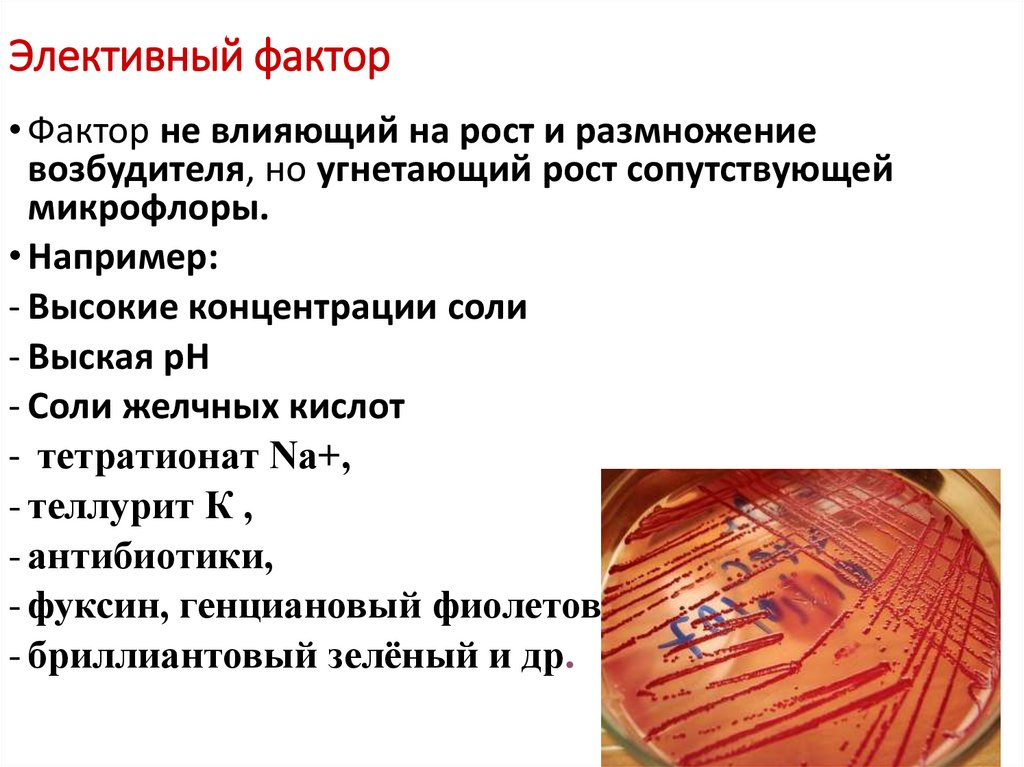
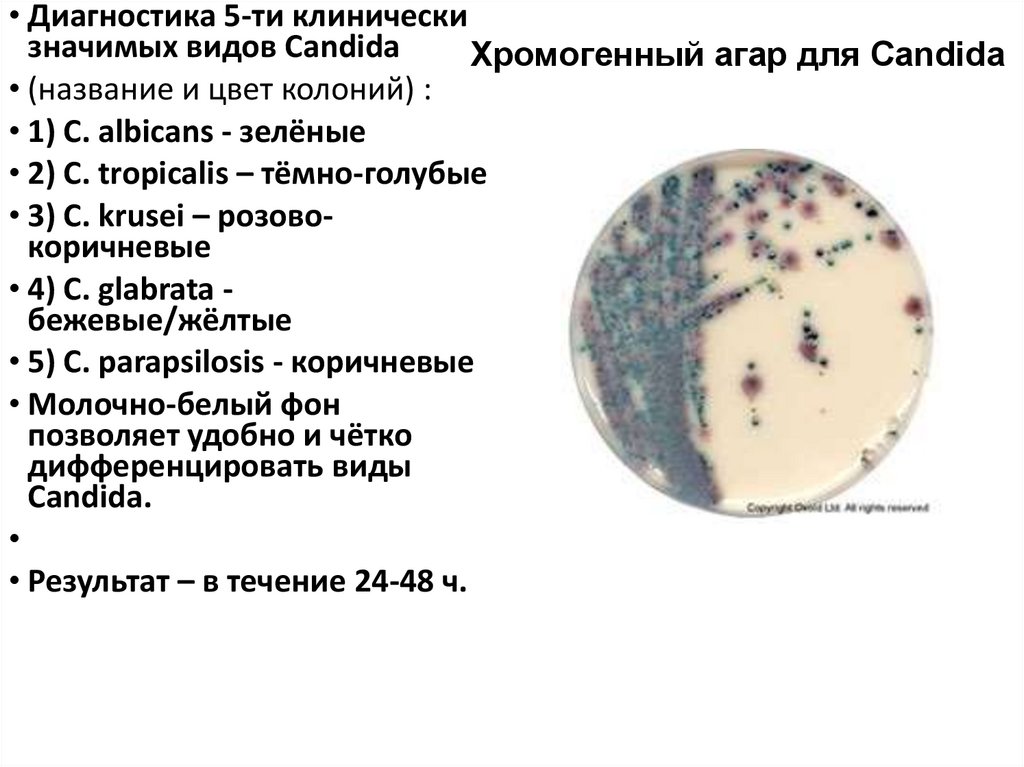
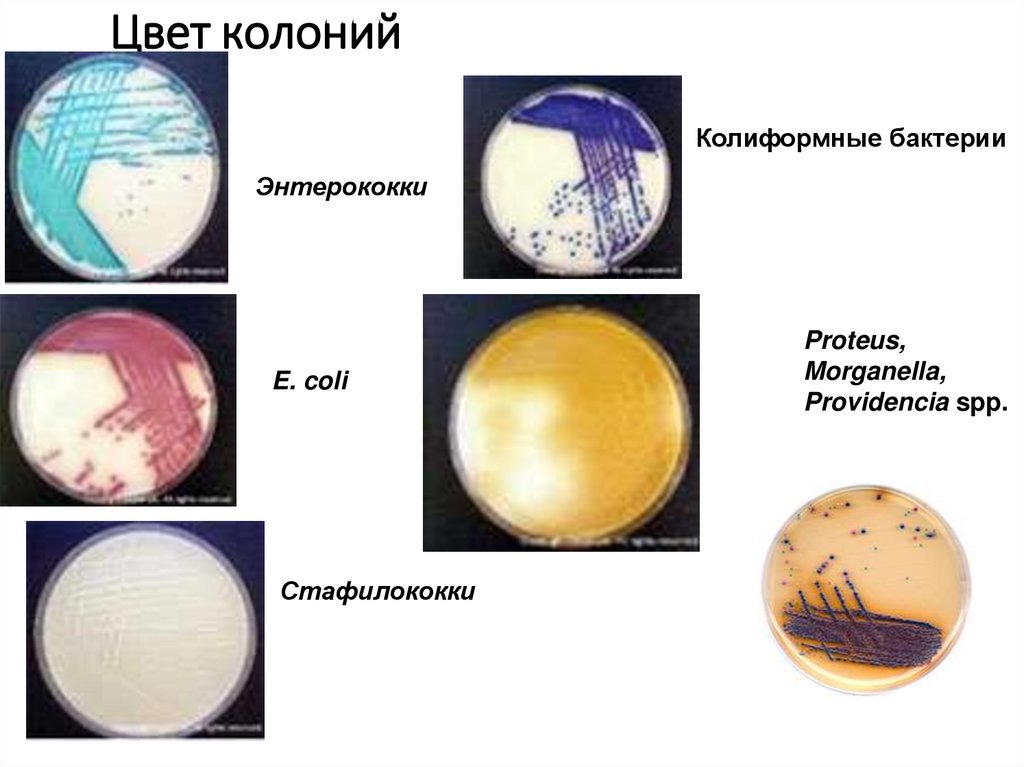
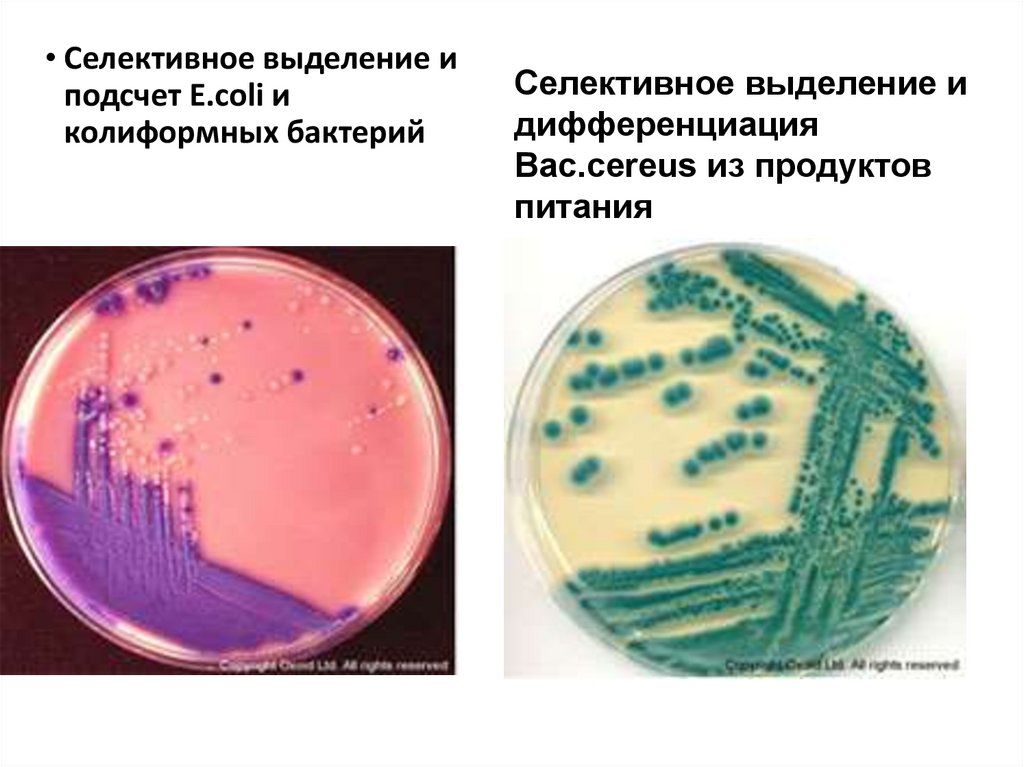

Похожие презентации:
Питательные среды в микробиологии
1. Питательные среды в микробиологии
2.
• ОРГАНОГЕНЫ [от орган и ...ген(ы)] - химическиеэлементы, играющие ту или иную роль в жизни
организмов.
• К органогенам относится 21 элемент, среди которых Б. Б.
Полынов (1968) выделил абсолютные органогены без
которых невозможно существование жизни :
• кислород,
• водород,
• углерод,
• азот,
• марганец, калий, сера)
и специальные органогены (кремний, натрий, кальций, железо,
фтор, магний, стронций, бор, цинк, медь, бром, йод), которые
необходимы многим, но не всем организмам.
3. Факторы роста
• Ауксотрофы - микроорганизмы, утратившие способность ксамостоятельному синтезу какого–либо метаболита (аминокислоты,
витамины, азотистые основания и др.) в результате мутации и потери
способности к образованию соответствующих ферментов.
• Ауксотрофы могут расти только на средах, в которые добавлен данный
метаболит (фактор роста)
4. Элективный фактор
• Фактор не влияющий на рост и размножениевозбудителя, но угнетающий рост сопутствующей
микрофлоры.
• Например:
- Высокие концентрации соли
- Выская рН
- Соли желчных кислот
- тетратионат Na+,
- теллурит К ,
- антибиотики,
- фуксин, генциановый фиолетовый,
- бриллиантовый зелёный и др.
5. Требования к питательным средам:
• Питательные среды должны содержать универсальныеисточники углерода, азота.
• Они должны являться источником витаминов и
минералов.
• В средах рН должно поддерживаться на постоянном
уровне, что обеспечивается наличием в питательных
средах буферных систем.
• Питательная среда должна быть стерильной.
• Питательная среда должна быть прозрачной.
• В ней должна быть оптимальная концентрация
кислорода и углекислого газа.
6. Этапы приготовления
• варка: среды варят на открытом огне, водяной бане,автоклавеили варочных котлах.
• установление pH: ориентировочно производят с помощью
индикаторной бумаги. При стерилизации pH снижается на 0,2,
поэтому сначала готовят более щелочной раствор.
• осветление производят, если при варке среды мутнеют или
темнеют.
• фильтрация жидких и расплавленных желатиновых сред
производят через влажный бумажный или матерчатый
фильтры.
• разливают среды не более чем на ¾ емкости, так как при
стерилизации могут намокнуть пробки и среды утратят
стерильность.
• стерилизация: режим стерилизации зависит от состава среды и
указан в её рецепте.
• контроль
7. Среды классифицируют по консистенции, составу, назначению
классификация по консистенции :• жидкие.
• полужидкие
• плотные
8.
• Агар-Агар – это разновидность красных водорослей, которые произрастают в основном на побережье Тихогоокеана в странах Азии, Мексики и
Калифорнии.
Агар-агар не растворим в холодной воде, однако легко и быстро растворяется в горячей
(Т плавления 86 гр.С). При охлаждении полученного раствора
образуется прозрачный гель
( Т застудевания -40 – 42 гр.С).
Агар-агар широко применяется в
микробиологии и пищевой промышленности.
В частности, на основе агар-агара
готовят гелеобразные питательные
среды для культивирования
микроорганизмов.
9.
По назначению:• консервирующие среды (для первичного посева и транспортировки),
• среды обогащения (для накопления определённой группы бактерий),
• среды для культивирования микроорганизмов:
- универсальные или простые
- сложные специальные:
- дифференциально-диагностические
- элективно-дифференциальные.
10.
При классификации питательных сред по составу :• выделяют белковые,
• безбелковые
• минеральные среды.
При классификации питательных сред по происхождению
• искусственные
• естественные (природные).
11. Консервирующие питательные среды
•предупреждаютотмирание патогенов
и подавляют рост
сапрофитов.
Наибольшее применение нашли
глицериновая смесь
(среда Тйга), гипертонический раствор,
глицериновый
консервант с LiCl2,
раствор цитрата натрия
и дезокси-холата
натрия (среда
Бенгсанга-Эллиота).
12. Транспортные среды
• Среда Стюарта представляет собой полужидкий,бедный питательными веществами субстрат для
сохранения и транспортировки широкого спектра
патогенных микроорганизмов, таких, как Neisseria
gonorrhoeae, Haemophilus influenzae, Corynebacterium
diphteriae, Trichomonas vaginalis, Streptococcus sp.,
Salmonella sp., Shigella sp. и др.
• Наиболее требовательные микроорганизмы
сохраняются в данной среде более суток, прочие – до
нескольких дней.
• Наличие в среде тиогликолата подавляет
ферментативную активность бактерий, а отсутствие азота
предотвращает их размножение.
13. Среды обогащения для бактерий
• Назначение: накопление возбуди-теля за счётсоздания оптимальных условий для
размножения
• Состав: питательная основа + факторы роста +
элективный фактор
• Примеры: среда Китта-Тароцци, селенитовый
бульон, сахарный бульон, тиогликолятная
среда и др.
14. Дифференциально-диагностические среды
1. Назначение: Выделение чистой культурывозбудителя. Используют ППС
2. Назначение: Изучение биохимической активности
культуры. Используют ЖПС и П\Ж
Состав: питательная основа +, дифференциру-ющий
фактор + индикатор
Примеры:
15.
•среды Гисса, Кларка) применяют для изучения иидентификации отдельных типов, видов и групп
бактерий. В качестве основы применяют
различные органические и неорганические
соединения, гидролизаты казеина, пептонную
воду и 0,5% раствор определен-ного углевода
(глюкоза, лактоза, мальтоза, манит, сахароза и
др.) и индикатор Андреде (кислый фуксин в
растворе NaOH). Среда при рН 7,2-7,4 –
бесцветна, при ферментации углеводов
приобретает красный цвет . В пробирки со
средой помещают поплавок (небольшая
трубочка, один конец которой запаян) для
улавливания газообразных продуктов,
образующихся при расщеплении углеводов.
16. Среды Гисса
17. Среды, содержащие углеводы или многоатомные спирты.
• Ферментативное расщепление субстратов приводит к сдвигу рН иизменению окраски среды, а иногда и образованию газа.
• Наиболее распространены цветные среды с различными
углеводами (например, с бромтимоловым синим, индикатором
ВР), лакмусовое молоко (среда Минкевича) и среды Гисса.
• Из углеводов наиболее часто используют
• моносахариды (ксилозу, арабинозу, глюкозу, фруктозу, маннозу,
галактозу),
• дисахариды (лактозу, мальтозу, сахарозу), полисахариды
(крахмал, гликоген, инулин, декстрин), спирты (дульцит, маннит,
сорбит, глицерин) и
• гликозиды (адонит, инозит, салицин, амигдалин).
18. Элективные и селективные питательные среды
• Назначение:первичный посев материала или для пересева сконсервирующих сред или сред обогащения
• Цель: получение чистой культуры.
• Состав: питательная основа+ элективный фактор +
дифференцирующий фактор +_ индикатор
• Примеры:кровяные и сывороточные среды (например,
Леффлера, Борде-Жангу), яичные среды (например,
Левенштайна-Йенсена) и др.
19.
• Диагностика 5-ти клиническизначимых видов Candida
Хромогенный агар для Candida
• (название и цвет колоний) :
• 1) C. albicans - зелёные
• 2) C. tropicalis – тёмно-голубые
• 3) C. krusei – розовокоричневые
• 4) C. glabrata бежевые/жёлтые
• 5) C. parapsilosis - коричневые
• Молочно-белый фон
позволяет удобно и чётко
дифференцировать виды
Candida.
• Результат – в течение 24-48 ч.
20. Цвет колоний
Колиформные бактерииЭнтерококки
E. coli
Стафилококки
Proteus,
Morganella,
Providencia spp.
21.
• Селективное выделение иподсчет E.coli и
колиформных бактерий
Селективное выделение и
дифференциация
Bac.cereus из продуктов
питания
22.
Питательные среды• Контрольные вопросы:
• 1.Требования к питательным средам.
• 2.Органогены.
• 3.Фактор роста.
• 4.Элективный фактор.
• 5.Этапы приготовления питательных сред.
• 6.Классификация питательных сред
• -общие среды (простые)
• -специальные среды:
• обогащения
• элективно - дифференциальные
• дифференциально - диагностические

Биология
Биология








